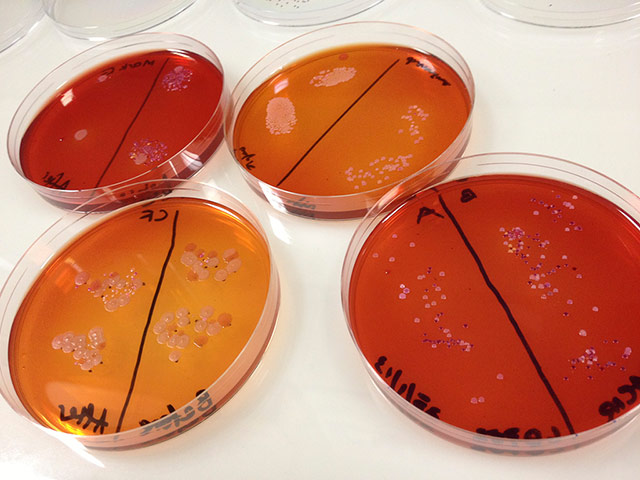
Broadvision: Broad Vision microbiology exercsise, thumbprints before and after cleaning

Photograph: Broad Vision 2013/Guardian

Photograph: Broad Vision 2013/Guardian

Photograph: Graeme Robertson/Guardian

Photograph: Graeme Robertson/Guardian
Photograph: Broad Vision 2013/Guardian

Photograph: Graeme Robertson/Guardian

Photograph: Broad Vision 2013/Guardian

Photograph: Broad Vision 2013/Guardian

Photograph: Broad Vision 2013/Guardian

Photograph: Broad Vision 2013/Guardian

Photograph: Broad Vision 2013/Guardian

Photograph: Broad Vision 2013/Guardian

Photograph: Broad Vision 2013/Guardian

Photograph: Broad Vision 2013/Guardian

Photograph: Broad Vision 2013/Guardian







